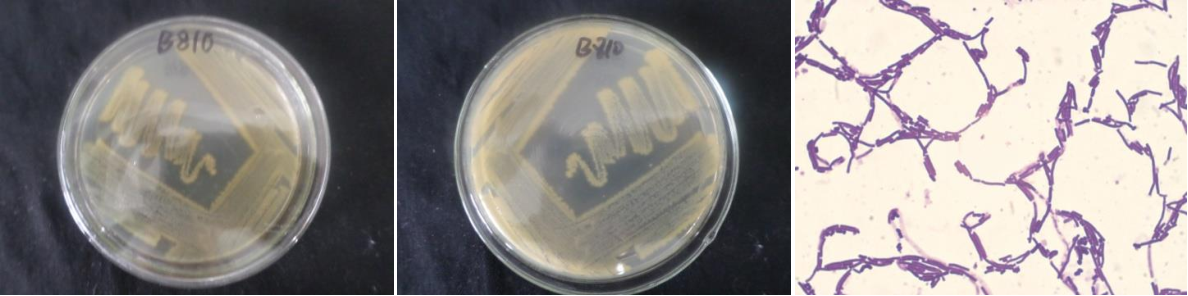

Loading...
| StrainNO | B810 |
| Classification | Bacillus |
| 16s rDNA sequence | CGAACTGATTAGAAGCTTGCTTCTATGACGTTAGCGGCGGACGGGTGAGTAACACGTGGGCAACCTGCCTGTAAGACTGGGATA ACTTCGGGAAACCGAAGCTAATACCGGATAGGATCTTCTCCTTCATGGGAGATGATTGAAAGATGGTTTCGGCTATCACTTACA GATGGGCCCGCGGTGCATTAGCTAGTTGGTGAGGTAACGGCTCACCAAGGCAACGATGCATAGCCGACCTGAGAGGGTGATCGG CCACACTGGGACTGAGACACGGCCCAGACTCCTACGGGAGGCAGCAGTAGGGAATCTTCCGCAATGGACGAAAGTCTGACGGAG CAACGCCGCGTGAGTGATGAAGGCTTTCGGGTCGTAAAACTCTGTTGTTAGGGAAGAACAAGTACGAGAGTAACTGCTCGTACC TTGACGGTACCTAACCAGAAAGCCACGGCTAACTACGTGCCAGCAGCCGCGGTAATACGTAGGTGGCAAGCGTTATCCGGAATT ATTGGGCGTAAAGCGCGCGCAGGCGGTTTCTTAAGTCTGATGTGAAAGCCCACGGCTCAACCGTGGAGGGTCATTGGAAACTGG GGAACTTGAGTGCAGAAGAGAAAAGCGGAATTCCACGTGTAGCGGTGAAATGCGTAGAGATGTGGAGGAACACCAGTGGCGAAG GCGGCTTTTTGGTCTGTAACTGACGCTGAGGCGCGAAAGCGTGGGGAGCAAACAGGATTAGATACCCTGGTAGTCCACGCCGTA AACGATGAGTGCTAAGTGTTAGAGGGTTTCCGCCCTTTAGTGCTGCAGCTAACGCATTAAGCACTCCGCCTGGGGAGTACGGTC GCAAGACTGAAACTCAAAGGAATTGACGGGGGCCCGCACAAGCGGTGGAGCATGTGGTTTAATTCGAAGCAACGCGAAGAACCT TACCAGGTCTTGACATCCTCTGACAACTCTAGAGATAGAGCGTTCCCCTTCGGGGGACAGAGTGACAGGTGGTGCATGGTTGTC GTCAGCTCGTGTCGTGAGATGTTGGGTTAAGTCCCGCAACGAGCGCAACCCTTGATCTTAGTTGCCAGCATTTAGTTGGGCACT CTAAGGTGACTGCCGGTGACAAACCGGAGGAAGGTGGGGATGACGTCAAATCATCATGCCCCTTATGACCTGGGCTACACACGT GCTACAATGGATGGTACAAAGGGCTGCAAGACCGCGAGGTCAAGCCAATCCCATAAAACCATTCTCAGTTCGGATTGTAGGCTG CAACTCGCCTACATGAAGCTGGAATCGCTAGTAATCGCGGATCAGCATGCCGCGGTGAATACGTTCCCGGGCCTTGTACACACC GCCCGTCACACCACGAGAGTTTGTAACACCCGAAGTCGGTGGAGTAACC |
| Strain Morphology Photos | |
| Morphological Description | Colony round;Apricot yellow;edge serrated;Convex in the middle;concave in the center;radial wrinkles;slippy;sticky;waxy;strain:Rod;having spore;Spores are intermediate |